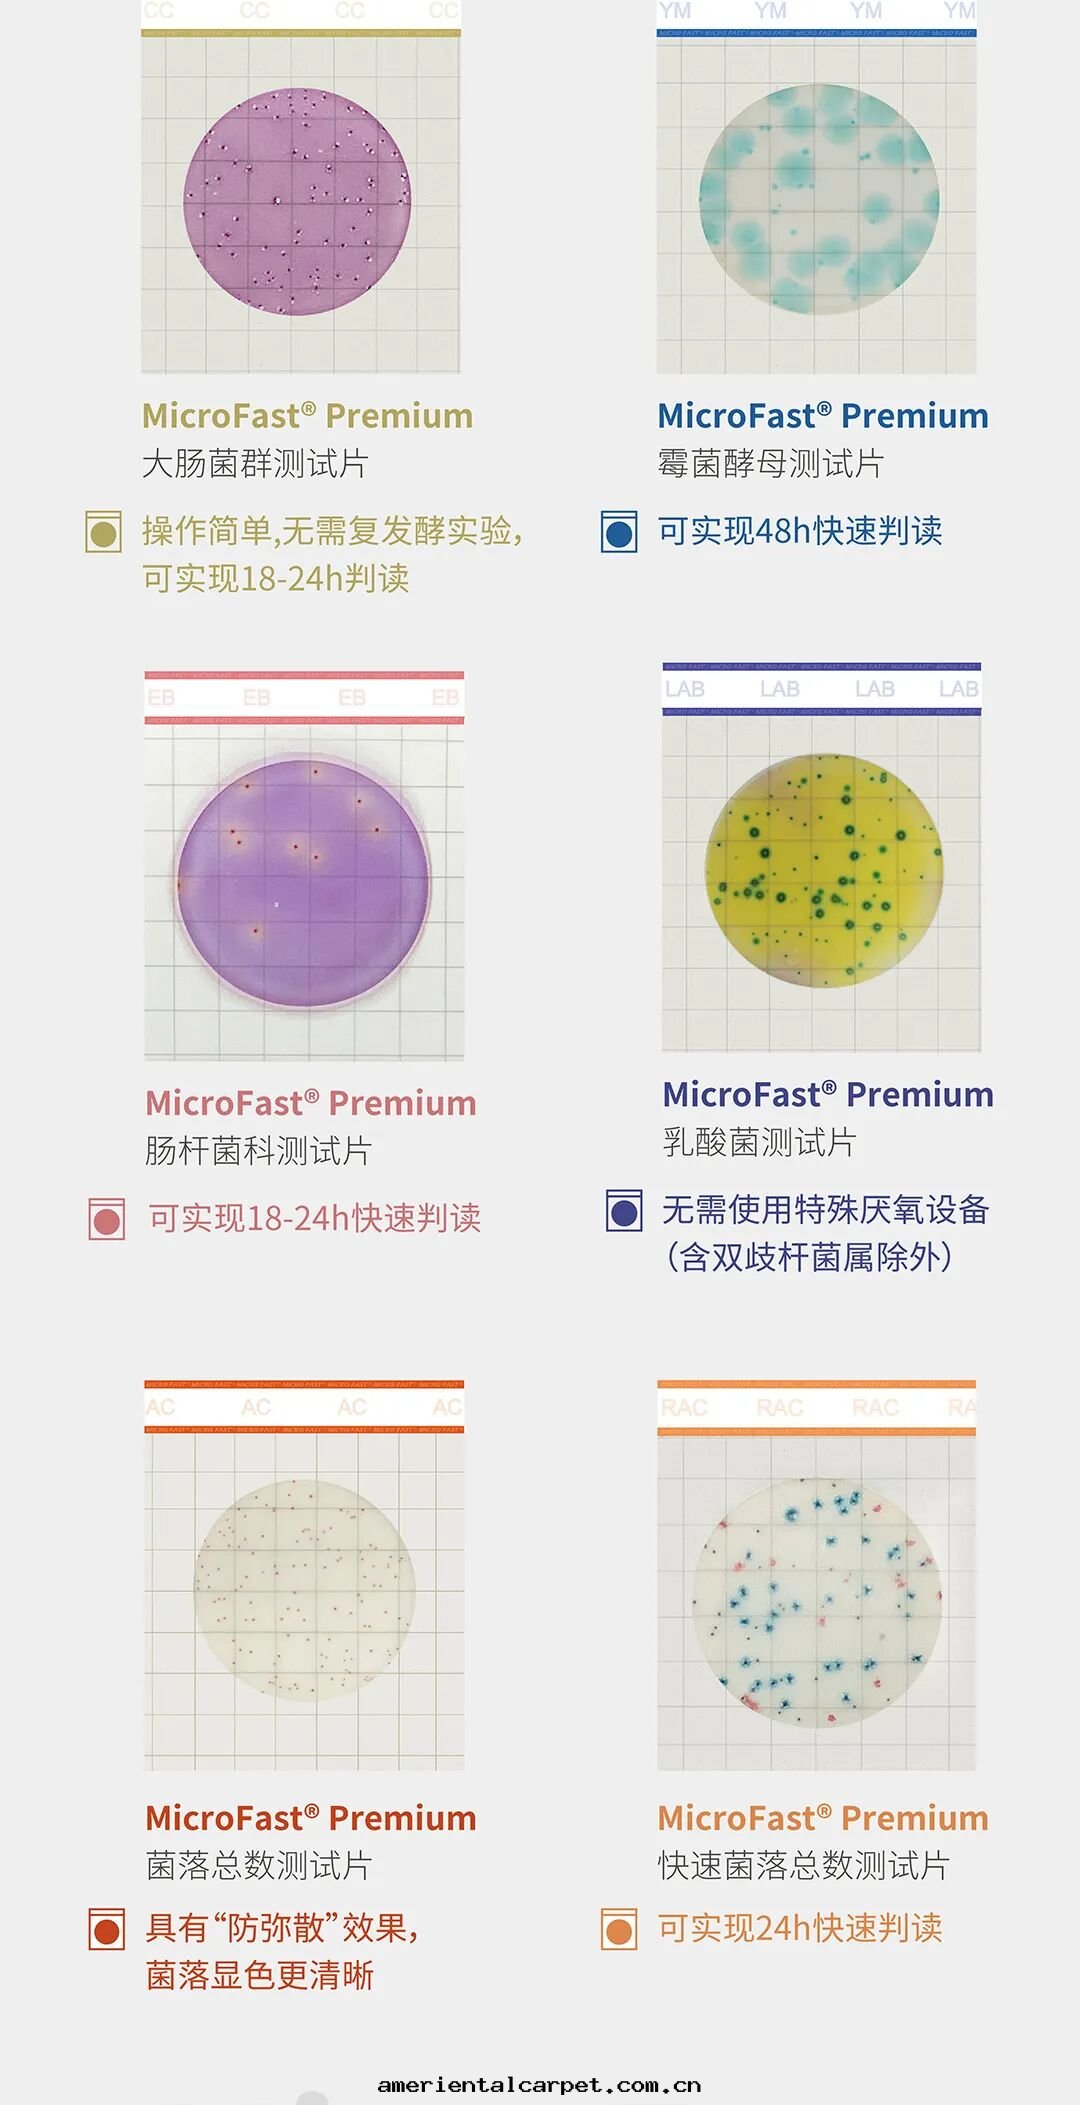
3.jpg

NEWS
新(xīn)聞資訊
開(kāi)年(nián)“快(kuài)”人一(yī)步:美(měi)正(zhèng)Premium測试片(piàn)又双(shuāng)叒叕上(shàng)新(xīn)啦!
2026-01-15 17:19浏览量(liàng):90
- 产品及解(jiě)決方(fāng)案(àn)
- 食品安全(quán)快(kuài)速檢測
- 微生(shēng)物(wù)檢測
- 實(shí)验室(shì)檢測解(jiě)決方(fāng)案(àn)
- 關(guān)于(yú)我(wǒ)们(men)
- 榮譽資質(zhì)
- 企業大(dà)事(shì)件(jiàn)
- 企業文(wén)化(huà)

![]()
grM83gVdF gtyEllCq 9eq7ok RkDfzW8QcS bPKWAyo
fEsLDRJ 5CJYR RSXIZEySMY il0ctc2 RRoVXWc pyqqZNoJJ TacoGEqk
SB6XSZ
cWIaxH
-
-
-
wnLt6DYYg aJevwq0u -
-
- Lzq9Sxx
-
- O7pS9s
ycSnzv2
fOujeCCx3
-
-
- VTKJfUHoFj
-
-

魯公(gōng)网(wǎng)安備37110202000421号(hào)
魯公(gōng)网(wǎng)安備37110202000421号(hào)